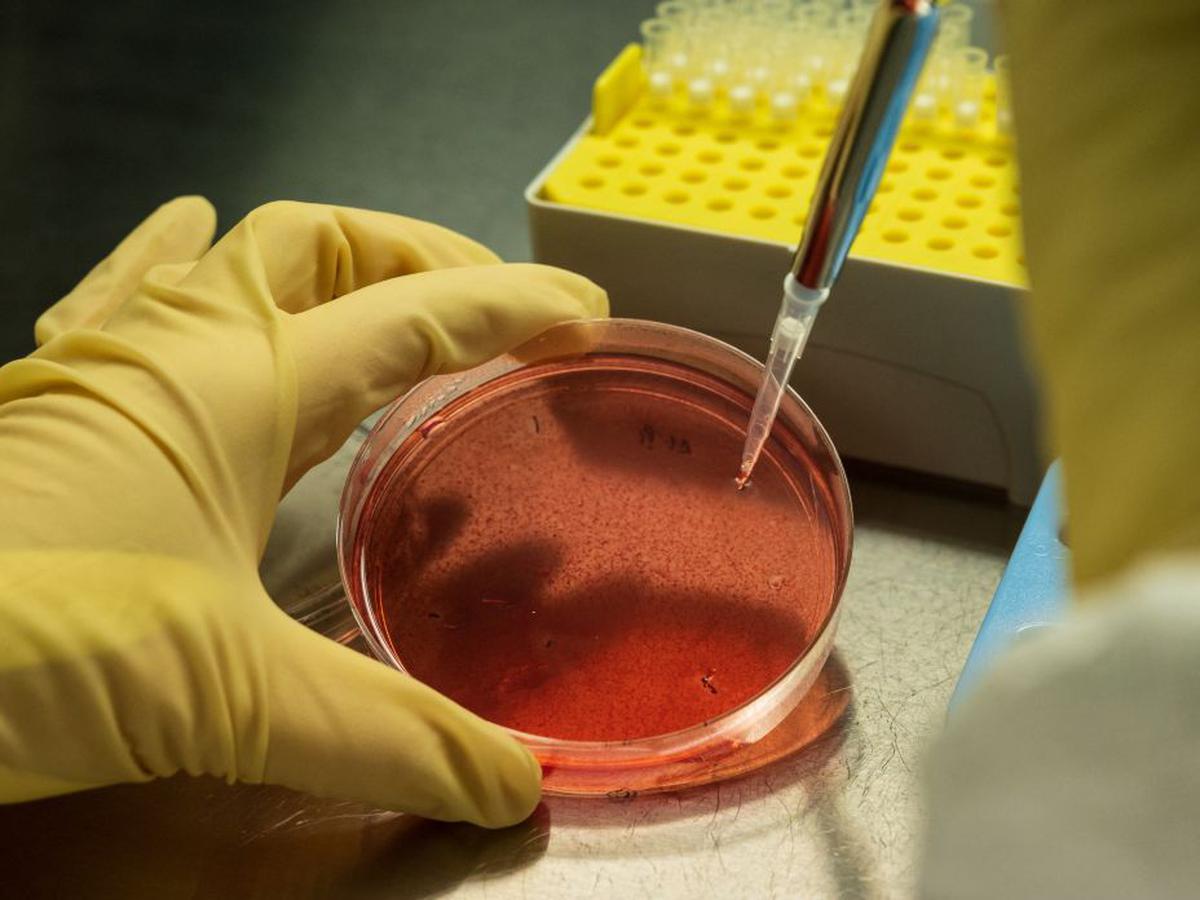
Esperanza

Recuerdo bien el puñetazo en forma de noticia que recibí hace unos años cuando un buen amigo me dijo que le habían diagnosticado un cáncer ... de colon. Fue una experiencia dolorosa para mi y demoledora para él. No obstante lo llevó bien y como si de una manera de defenderse y hacerle frente se tratara nunca creyó que aquello iría a mayores y que al final la enfermedad se lo llevaría por delante como así ocurrió. Lo trataron en la Clínica Universidad de Navarra en varias ocasiones y allí se trasladaba frecuentemente una vez que lo habían operado y extirpado el mal. De hecho en alguna ocasión coincidimos en Pamplona, él de visita médica y yo de visita más agradable a mis padres. Así transcurrió el tiempo.
A la operación siguieron otros tratamientos y, sobre todo, la quimio que lo dejaban hecho polvo. Pero lo llevaba bien. De hecho en algunas ocasiones llegó a trasladarse en su vehículo particular hasta Pamplona para pasar la revisión y volverse, una vez descansado, con una bolsa que le iba administrando el veneno 'salvador'. Pero al final ocurrió lo que, en un porcentaje demasiado elevado, tenía que pasar. Se produjo la metástasis y aquello ya fue una cuesta que, día a día, se hacía más pronunciada. Sobrevivió un tiempo a base de pastillas y de morfina para paliar los intensos dolores que padecía. Y finalmente, y en cuestión de pocos días, falleció.
Hasta poco antes de morir él nunca desfalleció ni admitió que estaba más allí que aquí. A pesar del deterioro de su cuerpo siempre pensó que vencería la enfermedad y que saldría adelante porque si algo tenía era ganas de vivir. Incluso hacíamos planes para cuando se encontrara mejor, pero la muerte le arrebató esas ansias por seguir vivo y a mí me privó de un buen amigo.
Me acuerdo con relativa frecuencia de mi amigo aunque ya hace unos cuantos años que murió. Y el jueves volví a hacerlo con nostalgia. En medio de este mundo y de unos tiempos en los que se hace difícil hasta seguir adelante porque no nos rodean más que calamidades, tristezas y malas noticias; en unos momentos en los que hasta te planteas el sentido de muchas cosas una buena noticia me llevó de nuevo a él.
El jueves conocimos que científicos del Instituto para la Investigación en Biomedicina de Barcelona, liderados por el biólogo Eduard Batlle, habían hecho un descubrimiento extraordinario. Los investigadores habían conseguido identificar en ratones las células causantes de la metástasis en el cáncer de colon. Pero no solo eso. También la manera de combatirlas mediante técnicas genéticas que podrían aplicarse antes de la cirugía. Este descubrimiento es de una importancia capital no sólo por detectarse esas células sino también porque se pueden combatir antes de la cirugía, dado que es a partir de ella cuando más casos de metástasis se produce. Esto abre una importante puerta a la esperanza para futuros enfermos entre los que nos podemos encontrar cualquiera de nosotros pues no en vano la Sociedad Española de Oncología Médica estima que este año se diagnosticarán en nuestro país 43.000 nuevos cánceres colorrectales; sin olvidar que el cáncer de colon es el que más personas mata en el mundo tras el de pulmón. Así pues, el alegrón tras conocer la noticia fue enorme porque, además, este descubrimiento y sus consecuencias se podrán aplicar casi con total seguridad a otros tipos de cáncer.
Por mi amigo, por los que ya han muerto, ya no podemos hacer nada, pero por los futuros enfermos nos debemos alegrar porque abrimos una ventana a la esperanza para acabar con una de las peores enfermedades que existen. Los que ya no están entre nosotros no van a volver, pero los que aquí quedamos podemos ser un poquito más optimistas que tal y como está el mundo hasta nos hemos olvidado de serlo o, cuando menos, no tenemos demasiados motivos para ello.
¿Tienes una suscripción? Inicia sesión